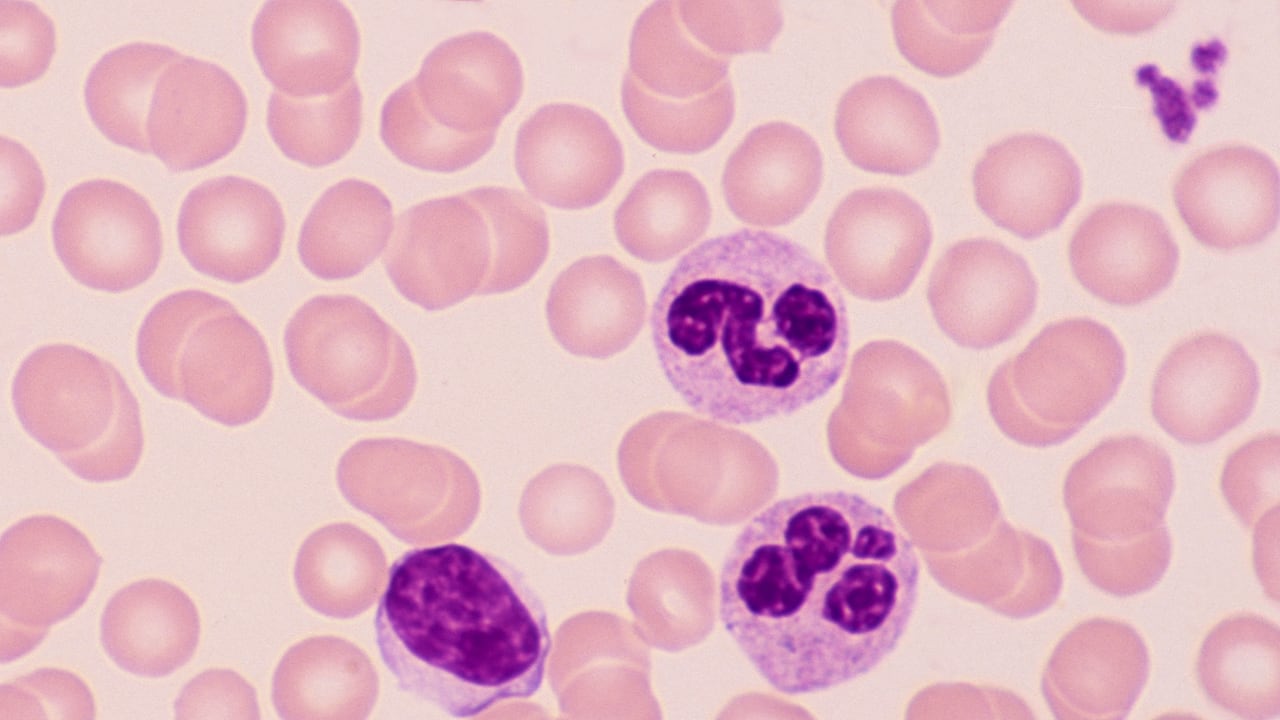
Imagen de referencia

Un nuevo modelo de aprendizaje automático llamado DreaMS acelera significativamente el análisis de moléculas previamente desconocidas, según una investigación publicada en la revista Nature Biotechnology.
El equipo incluye al ganador del Premio Neuron de este año para jóvenes científicos prometedores, Tomás Pluskal, del IOCB de Praga, junto con su estudiante Roman Bushuiev y sus colegas del Instituto Checo de Informática, Robótica y Cibernética de la Universidad Técnica Checa (CIIRC CTU), el Dr. Josef Sivic y Anton Bushuiev.
La naturaleza está llena de sustancias químicas aún por descubrir. Se cree que la gran mayoría de las moléculas naturales siguen siendo desconocidas. Describirlas podría allanar el camino hacia nuevos fármacos, pesticidas más respetuosos con el medio ambiente, una comprensión más profunda de los procesos biológicos o una investigación más avanzada sobre la vida en el universo.
Cada sustancia tiene un patrón único, similar a la huella dactilar humana, llamado espectro de masas, que puede capturarse mediante un método conocido como espectrometría de masas. Si bien este enfoque genera grandes cantidades de datos, interpretarlos y descubrir estructuras moleculares exactas es extremadamente difícil. Los conjuntos de datos resultantes suelen aparecer como extensas tablas de números sin un significado evidente.

Para desentrañar el misterio de las moléculas desconocidas, el equipo de IOCB y CIIRC CTU recurrió a la inteligencia artificial. Al igual que los grandes modelos lingüísticos como ChatGPT aprenden a comprender el lenguaje sin conocer de antemano el significado de las palabras, el modelo DreaMS intenta interpretar los espectros de masas sin conocer previamente sus estructuras químicas.

“ChatGPT puede inferir el significado de las palabras y las conexiones entre ellas a partir de grandes volúmenes de texto, y la red neuronal DreaMS, mediante aprendizaje automático autosupervisado, aprende a reconocer las estructuras moleculares ocultas en los espectros. Se basa en datos de millones de ejemplos”, explica Sivic en un comunicado.
“El modelo DreaMS se entrenó con decenas de millones de espectros de diversos organismos y entornos: plantas, microbios, alimentos, tejidos y muestras de suelo. Gracias a esto, puede descubrir similitudes ocultas entre espectros que, a primera vista, parecen no estar relacionados”, afirma Pluskal.
El resultado es una red interconectada que facilita la navegación por el vasto conjunto de datos químicos. Esta red, que puede imaginarse como una red de espectros de masas, se ha denominado Atlas DreaMS. Cada espectro es como un sitio web conectado a otros.
En esta “red de espectros”, los usuarios pueden buscar, explorar las conexiones descubiertas y plantear nuevas preguntas; por ejemplo: ¿Qué tienen en común los pesticidas, los alimentos y la piel humana?
DreaMS descubrió similitudes químicas inesperadas entre ellos y planteó la hipótesis de que ciertos pesticidas podrían estar relacionados con enfermedades autoinmunes como la psoriasis.
Además de conectar espectros de diferentes estudios, DreaMS también puede utilizarse para diversas tareas prácticas; por ejemplo, para estimar cuántos fragmentos específicos contiene una molécula o si incluye elementos químicos específicos.
“Nos sorprendió especialmente que el modelo aprendiera a detectar flúor”, afirma Bushuiev.

El flúor está presente en aproximadamente un tercio de todos los fármacos y agroquímicos, pero antes no podíamos detectarlo con fiabilidad a partir del espectro de masas. Tras preentrenar DreaMS con millones de espectros, lo perfeccionamos con miles de ejemplos de moléculas con flúor, y de repente funcionó.
Los investigadores ahora trabajan en el siguiente paso: enseñar al modelo a predecir estructuras moleculares completas. De tener éxito, podría transformar radicalmente nuestra comprensión de la diversidad química, tanto en la Tierra como en el resto del mundo, afirman los autores.
*Con información de Europa Press.